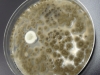
Mold picture- Black Mold Colonies

Yes, it is possible to keep mold from growing inside a building. Moisture control is the key to controlling mold in interior spaces. However it is not possible to keep a house or office completely free from mold spores since spores would always infiltrate from outdoors especially in summer.

Leave a Reply
You must be logged in to post a comment.